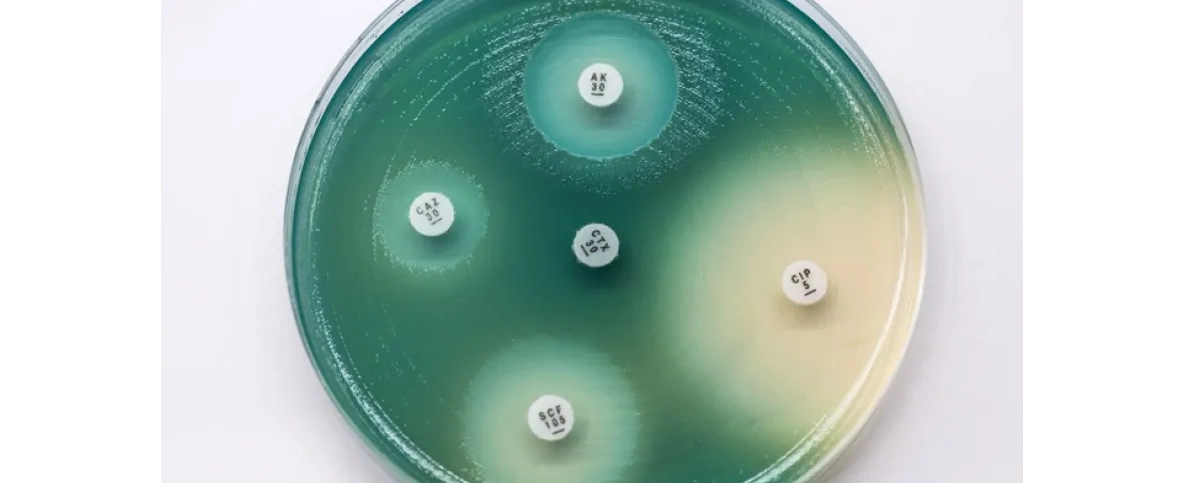
Gdańsk/ Naukowcy opracowali środek na pałeczkę ropy błękitnej

Naukowcy z Gdańska otrzymali patent na środek antybakteryjny skuteczny w zwalczaniu pałeczki ropy błękitnej – bakterii odpornej na antybiotyki, wywołującej groźne infekcje, zwłaszcza w szpitalach.
Centrum Transferu Technologii Uniwersytetu Gdańskiego poinformowało, że Urząd Patentowy RP przyznał patent zespołowi naukowców z Międzyuczelnianego Wydziału Biotechnologii Uniwersytetu Gdańskiego i Gdańskiego Uniwersytetu Medycznego, Wydziału Chemii Uniwersytetu Gdańskiego oraz Politechniki Gdańskiej.
Naukowcy opracowali preparat na bazie nanocząstek srebra i naftochinonu, który zwalcza pałeczkę ropy błękitnej poprzez hamowanie wzrostu i aktywne zabijanie komórek bakterii.
– Nasz preparat wykorzystuje zjawisko synergii srebra i naftochinonów, czyli wzajemnego zwiększania aktywności przeciwbakteryjnej obu składników. Dzięki synergii bardzo niskie dawki srebra i naftochinonu, które same w sobie nie działają, po połączeniu wykazują silne działanie bakteriobójcze – wyjaśniła kierownik zespołu dr Marta Krychowiak-Maśnicka. [...]
#nauka #medycyna #bakteriologia #bakterie #lekarstwo #patent #uniwersytetgdanski #naukawpolsce